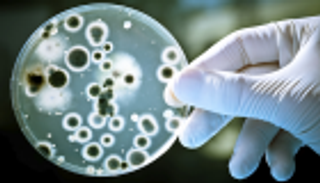

بالصور.. البكتيريا تشارك في تحدي الـ10 سنوات

طبيبة تشارك في تحدي الـ10 سنوات على طريقتها الخاصة، حيث نشرت صوراً مجهرية لتفاعل أنواع من البكتيريا مع مضادات متنوعة.
يواجه العالم اليوم خطراً محدقاً يتجسد في مقاومة البكتيريا للمضادات الحيوية المتوفرة بين أيدينا، وهو تهديد تعتبره منظمة الصحة العالمية الأكبر للأمن الغذائي والتنمية والصحة في العالم.
وبينما يشارك رواد مواقع التواصل الاجتماعي صورهم القديمة لإظهار تطور مظهرهم وتحسن لياقتهم أو تقدمهم في العمر في تحدي الـ10 سنوات الذي انتشر مؤخراً، شارك الأطباء بطريقتهم في التحدي نفسه، ناشرين صوراً مجهرية لتفاعل أنواع من البكتيريا مع مضادات متنوعة، الذي يظهر سرعة تطور تلك الكائنات الحية الدقيقة مقارنة بقدرتنا على تطوير أدوية تستطيع القضاء عليها، في محاولة لإلقاء الضوء على تلك الأزمة الطبية.
وتنقل صحيفة "ديلي ميل" البريطانية مشاركة الطبيبة كايت فلافين لصورة تظهر كبسولات من المضادات الحيوية في وسط بكتيري، وتفاعل هذا الوسط مع المضاد في الصورة القديمة عام 2009.
ويشرح أحد خبراء مقاومة البكتيريا للمضادات الحيوية للصحيفة أن كثافة البكتيريا في الصورة الحديثة عام 2019 لم تتغير بالمطلق، وهو ما يعكس أثر المضاد في الجسم كذلك، حيث اعتادت الجراثيم تلك المضادات حتى بطل أثرها.

ويفيد مركز السيطرة على الأمراض والوقاية منها في الولايات المتحدة بأن مليوني إنسان يصابون بعدوى مقاومة للبكتيريا، فيما تودي الالتهابات بحياة 23 ألف شخص سنوياً، كما يتوقع المركز تفاقم ذلك التهديد في السنوات المقبلة، ويشير الاتحاد الأوروبي إلى أن 58 ألف رضيع ماتوا في سنة واحدة بسبب عدوى مضادة للبكتيريا، انتقلت إليهم من أمهاتهم.
يذكر أن أعداد البكتيريا المقاومة للمضادات الحيوية قد ازداد للضعف في أوروبا منذ عام 2007، وبنسب قريبة منها أو أكثر بقليل في بقية أرجاء العالم.